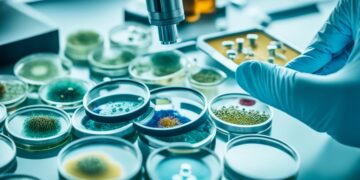
Amazing Discoveries

As the calendar turns, the natural world changes in a beautiful way. From spring's vibrant renewal to winter's quiet stillness, nature's rhythms change. These changes capture our senses and inspire...
Read moreDetailsBarbara Hall
In the world of healthcare, medical breakthroughs and revolutionary healthcare discoveries have changed how we see and treat health. These discoveries have led to life-saving medical innovations and new groundbreaking...
Read moreDetailsIn the vast, green landscapes of nature, wildflowers stand out with their bright colors and unique shapes. They're not just pretty; they're crucial for our planet's ecosystem. From sunny meadows...
Read moreDetailsElephants are truly remarkable creatures, known as the gentle giants of the natural world. They are the Earth's largest land mammals. These animals have many fascinating traits that capture the...
Read moreDetailsBiology has seen many amazing discoveries that have changed how we see the living world. From the groundbreaking theory of evolution to the mapping of the human genome, these discoveries...
Read moreDetailsWetlands are amazing ecosystems that play a key role in nature's balance. They are safe havens for many animals, giving them the resources they need to live. By learning about...
Read moreDetailsStep into the amazing world of animals, where the ordinary and the magical mix. Discover the incredible skills and strange behaviors that make us think differently. Meet creatures with amazing...
Read moreDetailsThe world of archaeology is full of amazing discoveries. These finds give us a peek into the captivating histories of long-lost civilizations. They show us ancient cities frozen in time...
Read moreDetailsDiscover the magic of nature right in your backyard! Learn how to watch wildlife and connect with the ecosystems around you. This guide is perfect for beginners and nature lovers...
Read moreDetailsModern medicine has seen huge changes thanks to groundbreaking discoveries. These have helped us understand DNA and create vaccines that save lives. These advances have changed healthcare for the better...
Read moreDetailsRecent News
How to Stay Healthy During the Winter
Amazing Discoveries in Medical Research
Categories
© PureInfoSpace